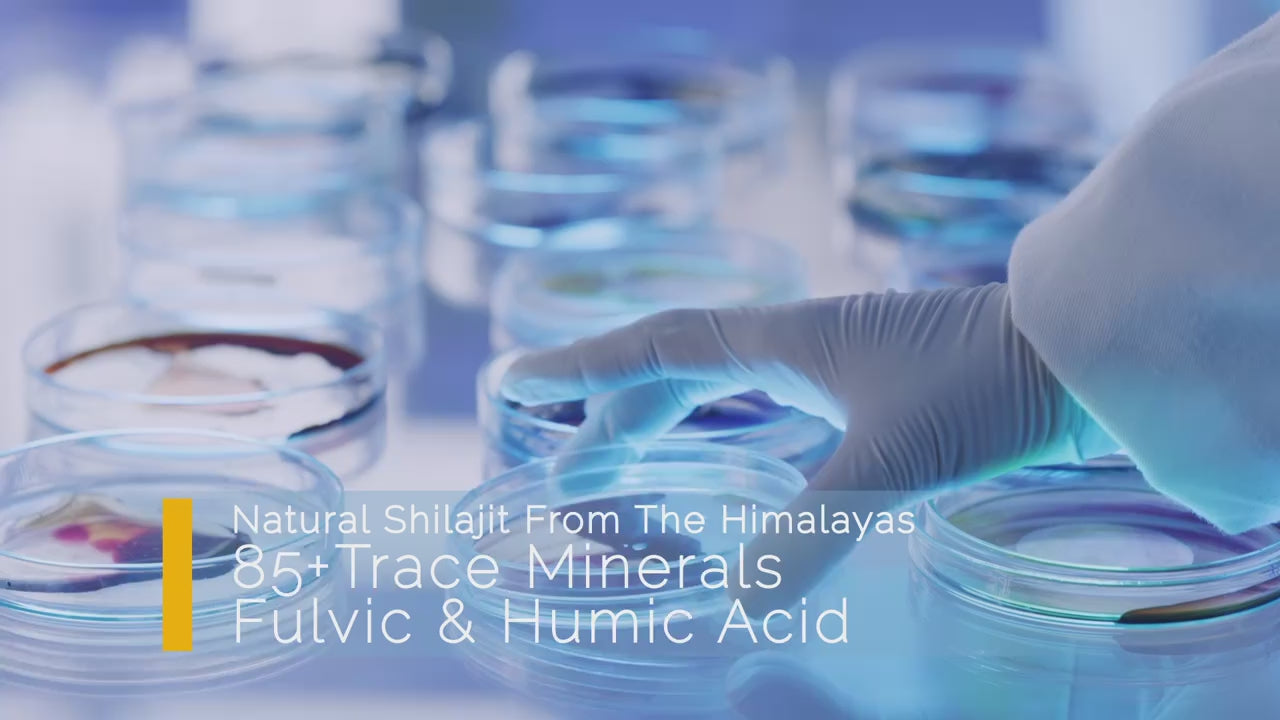

100% Pure Himalayan Organic Shilajit
100% Pure Himalayan Organic Shilajit
Couldn't load pickup availability
100% PURE GOLD LEVEL SHILAJIT -100% pure Siberian Altai Gold Grade Shilajit resin directly sourced from Siberian Altai Mountains at an altitude of 14,000 feet. The Shilajit resin wild harvested at this altitude is the premium gold level which has higher content of nutrients and purer than other shilajit products.
Rich in Over 85+ Trace Minerals & Fulvic Acids Shilajit naturally occurring minerals rich in fulvic acid, Humic compounds, and 85+ types of trace minerals. As everyone knows fulvic acid helps promote digestion and nutrient absorption. Trace mineral helps promote the body's metabolism, enhance the body's physical fitness and improve resistance.
Humanized Packaging HZOTO 50000 mg pure Shilajit resin has no chemical additives and no odor. Easy to absorb and nourish your body. Comes in a double-sealed, light-protected glass bottle to keep the Shilajit resin fresh and secure efficacy.
How to Use: Take 1/4 spoon (Approx. 600 mg) of Shilajit resin once or twice daily. Dissolve in luke warm water, your morning coffee or milk, stir and enjoy. Can also be taken directly under the tongue. Take 4-6 times per week for best results.
Shelf Life: 2 years
Usage:
✪Using the included measuring wooden spoon, take 600mg of shilajit resin daily.
✪Dissolve the resin in 1 cup of luke warm water, tea, your morning coffee or milk. Stir it up to mix it thoroughly.
✪Drink it on an empty stomach every morning or before other meals if you feel the need.
Can also be taken directly under the tongue for superior sublingual absorption.
✪For optimum results take 4-6 times per week.




Share